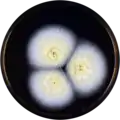
Aspergillus salwaensis growing on MEAOX plate

| Aspergillus salwaensis | |
|---|---|
| Scientific classification | |
| Domain: | Eukaryota |
| Kingdom: | Fungi |
| Division: | Ascomycota |
| Class: | Eurotiomycetes |
| Order: | Eurotiales |
| Family: | Aspergillaceae |
| Genus: | Aspergillus |
| Species: | A. salwaensis |
| Binomial name | |
| Aspergillus salwaensis C.M. Visagie, J. Houbraken, Fotedar, J.C. Frisvad & R.A. Samson (2014)[1] | |
Aspergillus salwaensis is a species of fungus in the genus Aspergillus. It is from the Circumdati section.[1] The species was first described in 2014.[1] It has been reported to produce penicillic acid.[1]
Growth and morphology
A. salwaensis has been cultivated on both Czapek yeast extract agar (CYA) plates and Malt Extract Agar Oxoid® (MEAOX) plates. The growth morphology of the colonies can be seen in the pictures below.
 Aspergillus salwaensis growing on CYA plate
Aspergillus salwaensis growing on CYA plate Aspergillus salwaensis growing on MEAOX plate
Aspergillus salwaensis growing on MEAOX plate
References
- 1 2 3 4 Visagie, C.M.; Varga, J.; Houbraken, J.; Meijer, M.; Kocsubé, S.; Yilmaz, N.; Fotedar, R.; Seifert, K.A.; Frisvad, J.C.; Samson, R.A. (2014). "Ochratoxin production and taxonomy of the yellow aspergilli (Aspergillus section Circumdati)". Studies in Mycology. 78: 1–61. doi:10.1016/j.simyco.2014.07.001. PMC 4255584. PMID 25492980.
This article is issued from Wikipedia. The text is licensed under Creative Commons - Attribution - Sharealike. Additional terms may apply for the media files.